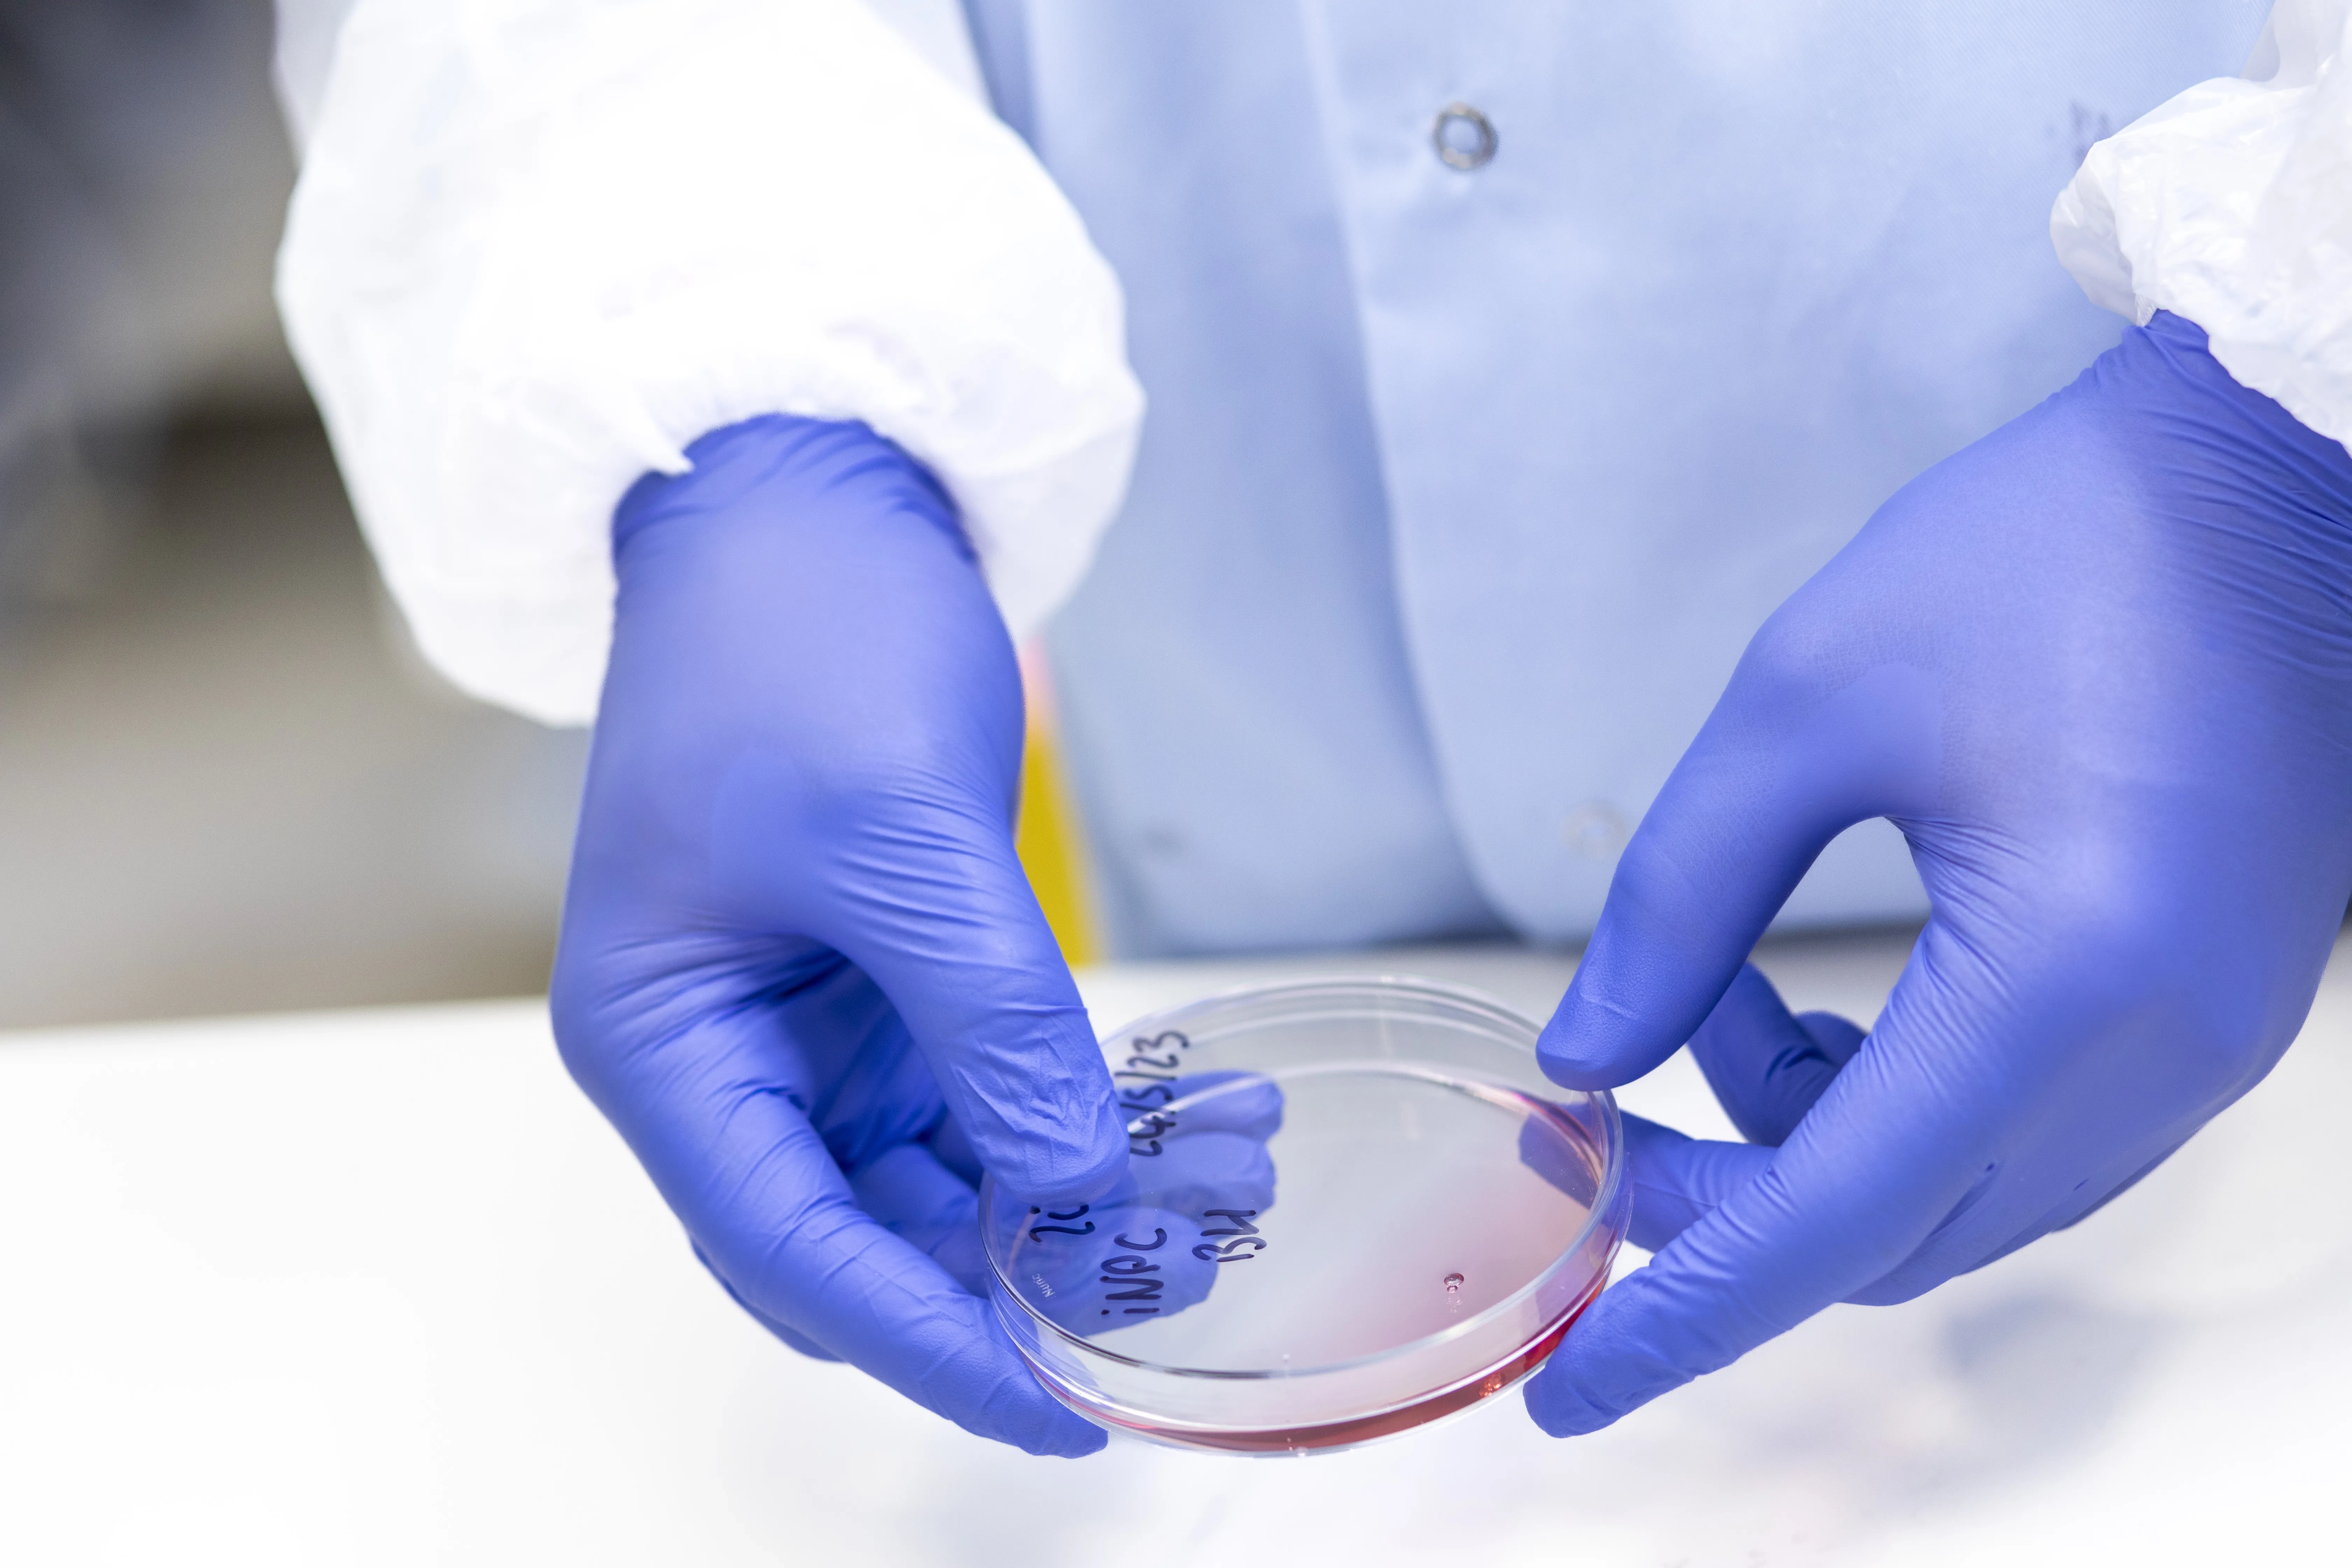

As a new chapter in Mike and Zoe's lives was about to begin, motor neurone disease changed their story.
“As I walked towards the restaurant to meet Zoe for the first time, I noticed a strange feeling in my left leg. A couple of months later, I was told I had MND.” Mike
Mike and Zoe met on the Channel 4 programme First Dates. That day changed both of their lives. They each found their soulmate. But as a bright new chapter was about to begin, MND was already, silently, cutting Mike’s life short.
MND is a devastating disease. It can run in our families, or it can strike us out of nowhere. Today and every day, 6 more people like Mike will be diagnosed with MND. Each one will be told that they will die early because of it and there’s nothing that can stop it or slow it down.
They’ll watch their bodies begin to fail as they lose the ability to bring up their children, support their families or do the things they had long dreamed they might do.
Will you help stop MND destroying people’s lives?
Mike and Zoe don’t know how his MND will develop. It could most affect Mike’s speech, his ability to walk or his independence. One thing is certain, MND will never take the love they have for each other. But it will take Mike’s life too young and too soon.
Love alone won’t find a cure for MND. But your donation today will. You could fund the research that figures out how we stop this disease.
In recent years MND researchers have made much progress. We’re beginning to understand why MND affects us and why it creates the damage it does. We’re seeing promise in potential treatments. As a charity we’ve invested millions and a cure is closer than ever.
To finally find it, we need you to become part of the story today too.
Please, bring light into the darkness of MND. Help us find a cure.
We have to change the story of MND. Will you help?
Will you support world-class research and vital care?
Dr Nick Cole, Head of Research at the MND Association explains how your donation could help.
“We’re fighting MND on every front. We’re funding ground-breaking research that will mean we can one day save the lives of people like Alex. But MND researchers need your support to make that happen.
“And until we find a cure, we’ll need to keep providing life-changing support and practical advice to people diagnosed with this devastating disease, and their families. Will you help them with a donation too?”
Yes, I want to help beat motor neurone disease today.
Donate now
£20
could help fund an MND Connect advisor, providing information and support to anyone affected by MND.